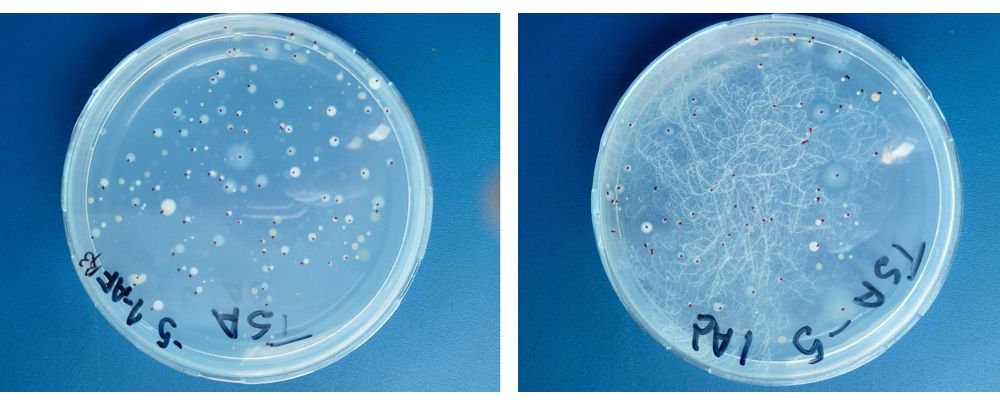

ECOLOGÍA MICROBIANA EN AGROECOSISTEMAS
Líneas de Investigación
El grupo liderado por la Dra. Zabaloy cuenta con amplia trayectoria en el estudio del microbioma del suelo en sistemas agrícolas bajo diversos manejos. Nuestro equipo ha empleado metodologías analíticas avanzadas para evaluar la actividad biológica, estructura, diversidad y abundancia de comunidades microbianas, abordando experimentos en distintas condiciones: incubaciones in vitro, estudios con plantas en invernadero y ensayos de campo. Estas investigaciones han explorado el impacto de regímenes de fertilización, enmiendas orgánicas y usos y manejos del suelo, tanto en microbiomas edáficos como en los de rizosfera. Además, el grupo posee experiencia en la biometanización de materiales orgánicos, incluyendo su caracterización, mineralización posaplicación y evaluación de su capacidad fertilizante. Este trabajo se ha desarrollado estudiando la química y física de suelos, biología de suelos y desarrollo de los cultivos, consolidando un enfoque integral para la gestión sostenible de los agroecosistemas.
El compromiso del grupo es contribuir con las líneas de investigación al desarrollo sostenible en el marco de "Una sola salud". Este paradigma reconoce la interdependencia entre la salud humana, animal, vegetal y ambiental, promoviendo soluciones multidisciplinarias para abordar desafíos globales como la resistencia a antimicrobianos, el cambio climático y la seguridad alimentaria.
Publicaciones recientes
Ver SIGEVA CONICET Dra. María Celina Zabaloy
- PGI UNS 24/A276 “Contribuciones de la Ecología Microbiana a la producción sustentable desde la perspectiva de "Una Salud". Directora: MC Zabaloy; codirector: GA Iocoli. Plazo de ejecución: 2024-2026.
- PICT 2020-02289 “Evaluación de la seguridad biológica y ambiental del uso de biofertilizante basado en digeridos anaeróbicos de estiércol y biocarbón sobre el sistema suelo-planta-microbioma”. Investigadora responsable: MC Zabaloy. Plazo de ejecución: 2022-2025
- PIP2021: "Estudio del microbioma de suelo y rizosfera bajo cultivo de cobertura y su relación con el control de Rhizoctonia solani, agente causal de la podredumbre de raíz en cereales". Investigadora responsable: MC Zabaloy. Plazo de ejecución: 2023-2025
- Dra. Jessica Basualdo (Asistente de Docencia, Departamento de Agronomía, UNS)
- Dr. Marco Allegrini (Investigador Asistente, IICAR, UNR-CONICET)
- Dra. María Bonita Villamil (Full Professor, Department of Crop Sciences, University of Illinois)
- Dra. Carolina V. Temperini (Investigadora Asistente, UNRN
- Cátedra de Fitopatología (Departamento de Agronomía, UNS)
Integrantes:
Dr. Gastón Alejandro Iocoli
Ingeniero Agrónomo y
Doctor en Agronomía, UNS
Investigador Asistente, CERZOS
Profesor Adjunto, Dedicación exclusiva.
Dpto. Agronomía – UNS
E-mail: 
Dra. Marianela E. Morales
Doctora en Agronomía
Becaria posdoctoral, CONICET
E-mail:
Dra. Camila Fabiani
Doctora en Biología
Becaria posdoctoral, CONICET
E-mail: 
Lic. María Victoria Valero
Lic. en Cs. Biológicas
Beca de posgrado, CONICET
E-mail: 
Ana María Zamponi
Técnica Principal, CONICET
Departamento de Agronomía UNS
E-mail: